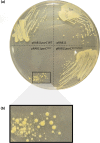

Large tandem chromosome expansions facilitate niche adaptation during persistent infection with drug-resistant Staphylococcus aureus
- PMID: 28348811
- PMCID: PMC5320569
- DOI: 10.1099/mgen.0.000026
Large tandem chromosome expansions facilitate niche adaptation during persistent infection with drug-resistant Staphylococcus aureus
Abstract
We used genomics to study the evolution of meticillin-resistant Staphylococcus aureus (MRSA) during a complex, protracted clinical infection. Preparing closed MRSA genomes from days 0 and 115 allowed us to precisely reconstruct all genetic changes that occurred. Twenty-three MRSA blood cultures were also obtained during treatment, yielding 44 colony morphotypes that varied in size, haemolysis and antibiotic susceptibility. A subset of 15 isolates was sequenced and shown to harbour a total of 37 sequence polymorphisms. Eighty per cent of all mutations occurred from day 45 onwards, which coincided with the appearance of discrete chromosome expansions, and concluded in the day 115 isolate with a 98 kb tandem DNA duplication. In all heterogeneous vancomycin-intermediate Staphylococcus aureus isolates, the chromosomal amplification spanned at least a 20 kb region that notably included mprF, a gene involved in resistance to antimicrobial peptides, and parC, an essential DNA replication gene with an unusual V463 codon insertion. Restoration of the chromosome after serial passage under non-selective growth was accompanied by increased susceptibility to antimicrobial peptide killing and reduced vancomycin resistance, two signature phenotypes that help explain the clinical persistence of this strain. Elevated expression of the V463 parC was deleterious to the cell and reduced colony size, but did not alter ciprofloxacin susceptibility. In this study, we identified large DNA expansions as a clinically relevant mechanism of S. aureus resistance and persistence, demonstrating the extent to which bacterial chromosomes remodel in the face of antibiotic and host immune pressures.
Keywords: Staphylococcus aureus; antibiotic resistance; chromosome duplication; evolution; genomics; mutation.
Figures

References
-
- Bayer A.S., Mishra N.N., Sakoulas G., Nonejuie P., Nast C.C., Pogliano J., Chen K.T., Ellison S.N., Yeaman M.R., Yang S.J. (2014). Heterogeneity of mprF sequences in methicillin-resistant Staphylococcus aureus clinical isolates: role in cross-resistance between daptomycin and host defense antimicrobial peptides Antimicrob Agents Chemother 587462–746710.1128/AAC.03422-14. - DOI - PMC - PubMed
-
- Berglund C., Söderquist B. (2008). The origin of a methicillin-resistant Staphylococcus aureus isolate at a neonatal ward in Sweden-possible horizontal transfer of a staphylococcal cassette chromosome mec between methicillin-resistant Staphylococcus haemolyticusStaphylococcus aureus Clin Microbiol Infect 141048–105610.1111/j.1469-0691.2008.02090.x. - DOI - PubMed
Data Bibliography
-
- Stinear, T. FigShare http://dx.doi.org/10.6084/m9.figshare.1394626 (2015) Table S4. - DOI
-
- Stinear, T. FigShare http://dx.doi.org/10.6084/m9.figshare.1391325 (2015) JKD6229.gb. - DOI
-
- Stinear, T. FigShare http://dx.doi.org/10.6084/m9.figshare.1391322 (2015) JKD6210.gb. - DOI
-
- Stinear, T. FigShare http://dx.doi.org/10.6084/m9.figshare.1391323 (2015) JKD6210p.gb. - DOI
-
- Seeman, T. GitHub https://github.com/tseemann/prokka (2015).
Associated data
LinkOut - more resources
Full Text Sources
Other Literature Sources

